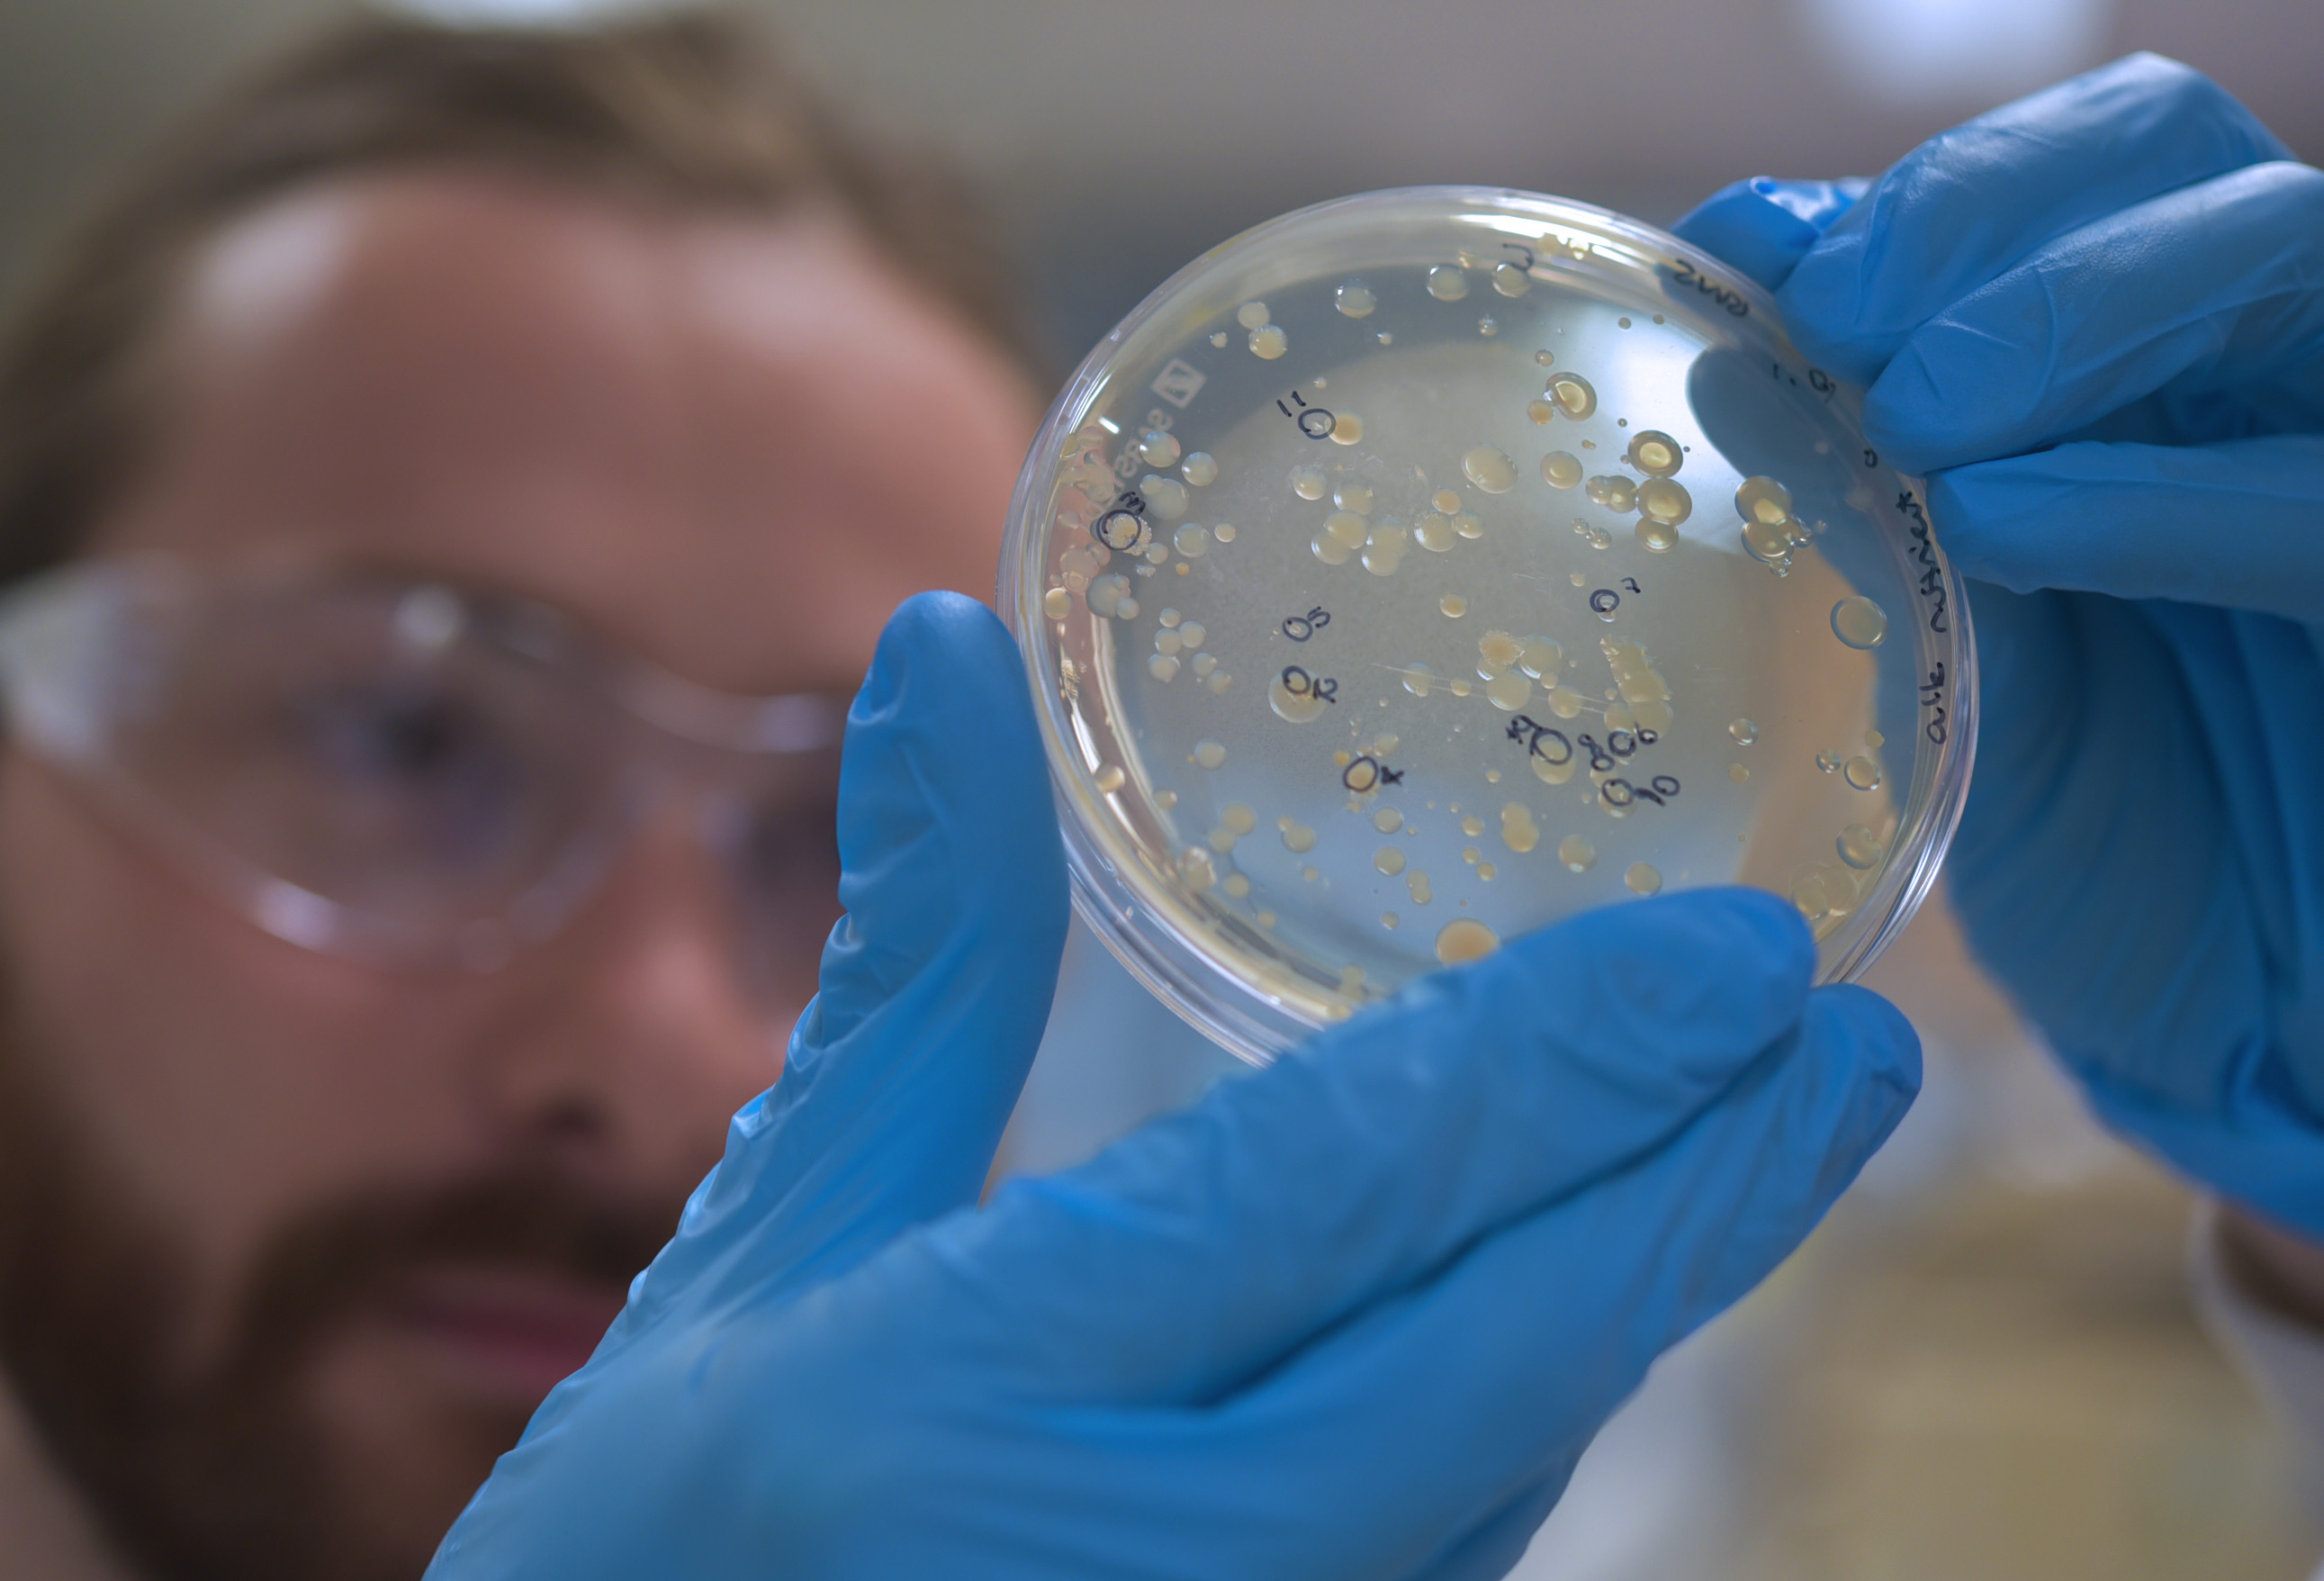

These jars are full of toxic red mud – a waste material produced by the tonne at mining sites across Australia.

In this form, it’s not much use to anyone.
But adding the right type of bacteria can help detoxify the sludge, and allow University of Queensland researchers like Dr Rosie Gillane, Fernanda Soto, and Luke Webster to extract valuable rare earth fragments.
“You wouldn’t usually associate bacteria or microorganisms with mine rehabilitation,” says Luke, whose PhD thesis is focused on ‘synbio’ mining techniques like the one he’s describing.

“It’s called biohydrometallurgy. Basically, we can use certain proteins to extract critical metals from red mud so they can be reused in sustainable technologies.
“The process is greener but not yet competitive for industry to adopt. If we can show that it can be done on an industrial scale, it’s a huge win for mining companies and sustainability.”
Biohydrometallurgy is itself not a new science. But Luke, Fernanda, and Rosie are working at the Australian Institute for Bioengineering and Nanotechnology (AIBN) to establish it as standard industry practice to cut pollution and open new value streams for mineral explorers.
This includes processing red mud from bauxite mining operations to recover hidden stores of nickel, cobalt, gallium, and other rare earth materials that are crucial to the production of electric vehicles and clean energy.
Rosie's groundbreaking research on extremophile microbes from mine waste environments is unlocking new possibilities for biomining. By isolating and cultivating these specialized organisms, she's paving the way for more efficient metal recovery and environmental remediation techniques. Stay on top of our industry news and developments, events and opportunities, by joining The NetworkJoin The Network
Fernanda, meanwhile, is leveraging engineering fungal strains adapted to the harsh conditions of red mud to produce organic acids that effectively bind to and isolate critical elements, potentially creating new metal extraction processes.
Overseeing the team’s research is the AIBN’s Dr Denys Villa Gomez, an Advance Queensland Research Fellow and associate investigator at the ARC Centre of Excellence in Synthetic Biology, who also leads synbio mining projects as the chief investigator at the ARC Training Centre in Critical Resources for the Future.

Using the equipment and expertise on hand at the AIBN, the School of Civil Engineering, and the newly established UQ Biosustainability Hub, Denys says her team is working hand in hand with industry to embed biomining as a sustainable and economically viable waste treatment option.
“Biomining has helped us recover a significant portion of the world’s copper and gold,” Denys says.
“However, the mine environment does limit how efficiently we can do this.
“With synthetic biology, we can engineer specific microbes that suit these extreme environments and allow us to carry out biomining processes at a larger scale.”
Much of the work done by Denys, Luke, Fernanda, Rosie, and the wider UQ Biosustainability Hub team revolves around harnessing biological processes to produce fuels, chemicals, ingredients, and other biomaterials in a more sustainable way.
The ‘BioHub’ – the first of its kind in Australia – aims to provide a one-stop-shop for industry wanting to partner with AIBN research teams to create carbon neutral and economically viable products.
Mining giant Rio Tinto is among the industry players already working with the BioHub, including working with Denys on a three-year Advance Queensland project to harness synthetic biology to recover critical minerals.
As well as securing a new stream of valuable minerals, Dr Rosie Gillane says she hopes the team’s red mud research will help build a stronger environmental legacy around mine rehabilitation.
“A lot of the materials we work with are really harsh waste products that can cause a lot of issues if they leach into waterways or soils,” Rosie says.
“So as well as unlocking new value, biohydrometallurgy is a process we can use to help remediate sites that could have otherwise remained a problem.”



